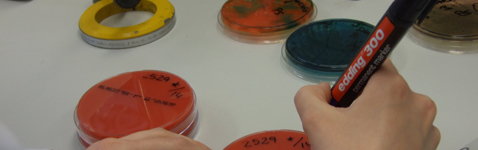

Análisis medioambientales
- Aguas de consumo: control en el grifo del consumidor, aguas de red del Canal YII, agua caliente sanitaria, fuentes, depósitos y aguas envasadas.
- Aguas continentales y subterráneas: pozos, piscinas, aguas recreativas, estanques.
- Investigación y recuento de gérmenes patógenos e indicadores de contaminación microbiológica en aguas de consumo según RD 3/2023.
- Análisis físico-químico y microbiológico en aguas de piscinas y otras aguas destinadas a usos recreativos.
- Investigación de Legionella en aguas de consumo e instalaciones de refrigeración.
- Determinación de metales pesados y Benzo(a)pireno en soportes de muestreo ambiental para evaluar la calidad del aire atmosférico según normativa de la UE.


























